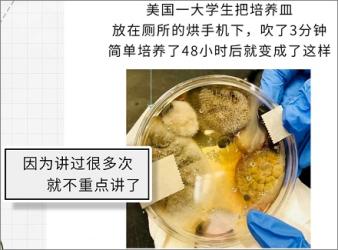
公共场所有哪些经常用的东西，其实很危险？！

内容预览
这将是一次特别的旅程!这将是一次难忘的体验!我决定带大家来次 city walk 逛逛公共场所小编你真好公共场所大家都没去过顺便教大家一点知识公共场所这 6 个东西千万不能随便乱碰首先我们来到的是公共厕所上完厕所后大家应该都会扯点纸擦擦屁股吧重点就来了
1. 公共厕所的纸巾别乱碰!暴露在空气中的纸巾本身就特别容易招揽细菌《我是大医生》节目组做过实验揣口袋里超过 48 小时的纸巾上面就发现了大量的大肠杆菌更别提以完全裸露的姿态直接暴露在公共厕所的纸巾说是细菌大本营一点都不过分直接接触私处就会带来不必要的隐患最常见的就是「尿路感染」那外面带盒的纸....省略之处更精彩
会员区